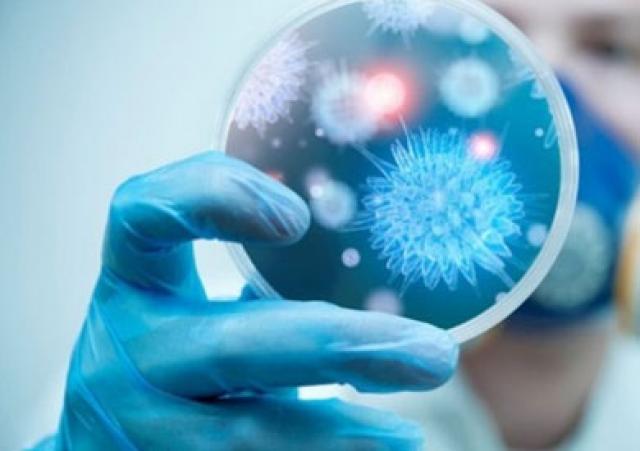
إصابة ممرضة هندية في السعودية بفيروس كورونا

إصابة ممرضة هندية في السعودية بفيروس كورونا
قال وزير الدولة للشؤون الخارجية في الهند ف. موراليدهاران اليوم الخميس إن ممرضة تعمل بأحد المستشفيات السعودية قد صارت أول هندية تصاب بفيروس كورونا الجديد الذي ظهر في الصين، وحصد أرواح 17 شخصا حتى الآن.
وقال موراليدهاران إنه تم إجراء اختبارات لحوالي 100 ممرضة يعملن في مستشفى الحياة بمدينة خميس مشيط ، في عسير بجنوب غرب المملكة، حيث تم اكتشاف إصابة واحدة بالفيروس.
وغرد الوزير على موقع "تويتر" للتواصل الاجتماعي: "الممرضة المصابة تتلقى العلاج بمستشفى الحياة الوطني - عسير وهي تتماثل للشفاء بشكل جيد"
يشار إلى أن العدد الأكبر من الممرضات المئة ينحدرن من ولاية كيرالا، بجنوب الهند.
ويمثل الهنود الذين يبلغ عددهم 6ر2 مليون شخص في السعودية هم الجالية الأكبر بالمملكة. ويعمل كثير من الممرضات الهنديات والمسعفين في مستشفيات ومراكز طبية في أنحاء البلاد.

 هيدر.jpg)
